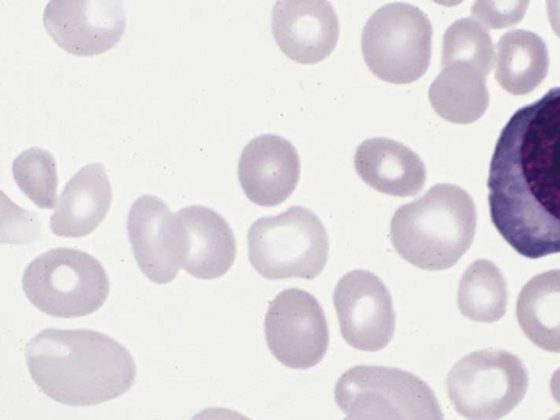

Les anti-inflammatoires non stéroïdiens (AINS) sont des options de traitement efficaces pour les crises de goutte, mais ils sont souvent associés à des effets secondaires. Des doses plus faibles de colchicine sont aussi efficaces et mieux tolérées que des doses élevées, mais elles n’ont jamais été comparées directement à un AINS. Une équipe de chercheurs vient de le faire.
La goutte est connue pour toucher plus d’hommes que de femmes. En Suisse, elle touche environ 3% des adultes de sexe masculin jusqu’à l’âge de la retraite. Elle provoque une flambée soudaine de douleurs et de gonflements articulaires, qui sont traités de manière standard par des anti-inflammatoires non stéroïdiens, de la colchicine à faible dose ou des corticostéroïdes.
De nombreuses études ont démontré que les AINS peuvent traiter efficacement les crises de goutte. Cependant, cela s’accompagne souvent d’effets secondaires importants, parfois mortels. Une étude a montré qu’en Grande-Bretagne, les trois quarts des médicaments prescrits pour cette pathologie entre 2001 et 2004 concernaient le diclofénac ou l’indométhacine, deux des AINS les plus toxiques. Le naproxène est associé à un risque vasculaire plus faible que les autres AINS et est aussi efficace que la prednisolone orale en cas de crise de goutte.
La colchicine à fortes doses est efficace, mais elle provoque souvent des effets secondaires gastro-intestinaux. Des doses plus faibles sont tout aussi efficaces, mais mieux tolérées. Pour aider les patients et les praticiens à choisir entre la colchicine à faible dose et le naproxène, le Dr Edward Roddy, du Primary Care Centre Versus Arthritis, School of Primary, Community and Social Care, Keele University, Royaume-Uni, et ses collègues ont entrepris une comparaison directe [1]. Leur étude CONTACT, randomisée, multicentrique et ouverte, avait pour objectif de comparer l’efficacité clinique du naproxène et de la colchicine à faible dose dans la réduction de la douleur causée par les crises de goutte en soins primaires, leurs profils d’effets secondaires et leur rapport coût-efficacité.
Première étude comparative directe
Les participants à l’étude ont reçu soit du naproxène oral 750 mg (trois comprimés de 250 mg), suivi de 250 mg (un comprimé) toutes les 8 heures pendant un maximum de 7 jours (la prescription simultanée d’un inhibiteur de la pompe à protons était laissée à la discrétion du médecin généraliste), soit de la colchicine orale 500 µg (un comprimé) toutes les 8 heures pendant 4 jours.
Il a été conseillé aux participants auxquels une statine avait été prescrite de suspendre la statine pendant le traitement par la colchicine. Les données de base ont été recueillies avant la randomisation par le biais d’un questionnaire auto-administré. Les résultats ont été recueillis par le biais d’un journal quotidien auto-administré (jours 1 à 7) et d’un questionnaire à la semaine 4.
L’issue primaire était une variation de l’intensité de la douleur la plus grave au cours des dernières 24 heures (échelle de notation numérique de 0 à 10) par rapport à la valeur initiale, mesurée quotidiennement pendant les 7 premiers jours : Le changement moyen par rapport à la valeur initiale a été comparé entre les groupes sur les jours 1 à 7 en utilisant l’intention de traiter.
399 participants ont été inclus dans l’étude : 200 ont reçu du naproxène et 199 de la colchicine. Les groupes étaient similaires au début de l’étude, bien que davantage de personnes du bras colchicine aient déclaré souffrir de crises de goutte pour la première fois. Les données sur les résultats primaires ont été recueillies pour 86% dans le groupe naproxène à J7 et 86,5% à 4 semaines. Dans le groupe colchicine, ce chiffre était de 88,9% dans les deux cas. Les auteurs de l’étude ont toutefois précisé que le diagnostic de la goutte avait été posé cliniquement chez les participants au lieu d’utiliser des critères validés ou des examens supplémentaires. En outre, ils considèrent comme des facteurs limitants le design ouvert sans évaluation des résultats à l’aveugle ou des comprimés placebo et la collecte de résultats rapportés exclusivement par les patients eux-mêmes, sans évaluation de l’effet des AINS sur des mesures objectives telles que la pression artérielle ou la fonction rénale.
Aucune différence significative
Il n’y a pas eu de différence significative entre les groupes en ce qui concerne les scores moyens de modification de la douleur au cours des jours 1 à 7 (colchicine vs naproxène : différence moyenne -0,18 ; intervalle de confiance à 95% [KI] -0,53 à 0,17 ; p=0,32). Pendant les jours 1 à 7, la diarrhée (45,9% vs 20% ; OR 3,31 ; IC à 95% 2,01-5,44) et les céphalées (20,5% vs 10,7% ; OR 1,92 ; IC à 95% 1,03-3,55) étaient plus fréquentes dans le groupe colchicine que dans le groupe naproxène, mais la constipation était moins fréquente (4,8% vs 19,3% ; OR 0,24 ; IC à 95% 0,11-0,54).
Dans les deux groupes, des améliorations du résultat primaire ont été observées au sein du groupe aux jours 1 à 7. (Fig. 1). Il n’y a pas eu de différence significative entre les groupes en ce qui concerne la variation moyenne de l’intensité de la douleur la plus grave au cours des jours 1 à 7 (colchicine vs naproxène : différence moyenne ajustée -0,18 ; IC à 95% -0,53 à 0,17 ; p = 0,32). À aucun moment, il n’y a eu de différence entre les groupes en ce qui concerne le soulagement complet de la douleur ou l’évaluation de la réponse au traitement par le patient. A la semaine 4, il n’y avait pas de différence entre les groupes en termes de rechute/crise de goutte récurrente, de consultation d’un médecin généraliste, d’une infirmière ou d’un service d’urgence.

Il y a eu trois événements indésirables graves, aucun lié aux interventions de l’étude et aucun décès. Deux participants ayant reçu du naproxène ont été hospitalisés : l’un pour des douleurs thoraciques non cardiaques et l’autre pour une pneumonie contractée à l’hôpital après l’implantation d’une valve aortique par transcathéter. Un participant ayant reçu de la colchicine a été hospitalisé pour une ostéomyélite. Entre les jours 1 et 7, la diarrhée et les maux de tête autodéclarés étaient plus fréquents avec la colchicine qu’avec le naproxène, tandis que la constipation était moins fréquente avec la colchicine (tableau 1). La diarrhée a atteint son maximum le La constipation a atteint son pic au 4e jour dans le groupe colchicine et au 3e jour dans le groupe naproxène. Les deux ont été considérablement réduits au cours des semaines 2 à 4.
Le Dr Roddy et ses collègues ont constaté des améliorations significatives de l’intensité de la douleur au sein de chaque bras dans les deux groupes, mais aucune différence statistiquement significative entre le naproxène et la colchicine à faible dose au cours des 7 premiers jours. Le naproxène a semblé fournir un soulagement plus rapide de la douleur, ce qui pourrait s’expliquer par le dosage de 750 mg, bien que la différence entre les groupes au jour 2 ait été plus faible et peut-être fausse. Les effets secondaires, notamment les diarrhées et les analgésiques, étaient plus fréquents avec la colchicine. Il n’y a pas eu de dommages majeurs avec le naproxène.

Il était inattendu que les maux de tête diffèrent entre les groupes, mais il semble plausible que le naproxène ait un effet protecteur pour les traiter ou les prévenir. La colchicine est considérée comme plus efficace si elle est administrée dans les 12 à 36 premières heures d’une crise de goutte. Les deux tiers des participants à l’étude ont commencé à prendre le médicament dans les 24 heures suivant l’apparition des symptômes, fournissant des preuves “du monde réel” que la colchicine à faible dose est efficace même lorsque le traitement est retardé par des facteurs liés au patient ou au service, écrivent les chercheurs. Le naproxène était légèrement moins cher que la colchicine en comparaison. Selon la conclusion du Dr Roddy et de ses coauteurs, les résultats suggèrent que le naproxène devrait être envisagé avant la colchicine à faible dose pour traiter les crises de goutte en soins primaires sans contre-indications.
Littérature :
- Roddy E, et al : Open-label randomised pragmatic trial (CONTACT) comparing naproxen and low-dose colchicine for the treatment of gout flares in primary care. Annals of the Rheumatic Diseases 2020 ; 79 : 276-284.
InFo DOULEUR & GERIATRIE